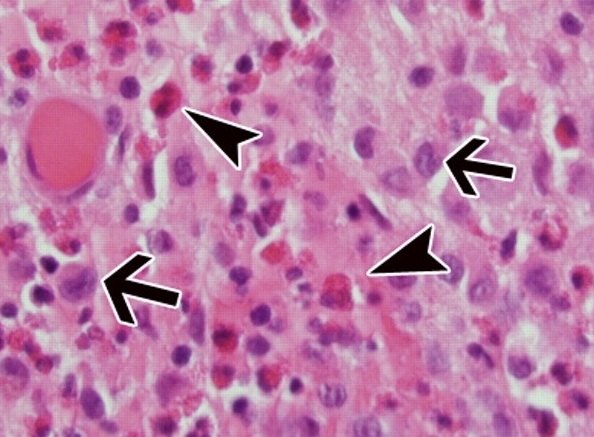
Гистиоцитоз из клеток Лангерганса

Рентгенограмма, КТ при лангергансоклеточном гистиоцитозе челюсти
Добавил пользователь Евгений Кузнецов Обновлено: 23.11.2025
а) Терминология:
1. Аббревиатура:
• Лангергансоклеточный гистиоцитоз (ЛКГ)
2. Синонимы:
• Эозинофильная гранулема (ЭГ), гранулематоз из клеток Лангерганса, гистиоцитоз X (икс)
• Клинические варианты: болезнь Хенда-Шуллера-Крисчена (Hand—Schuller—Christian), болезнь Леттерера-Сиве (ЛС) (Letterer-Siwe)
3. Определение:
• Неопластическая пролиферация клеток Лангерганса
б) Визуализация:
1. Общая характеристика:
• Локализация:
о Плоские кости: 65-70%:
- Кости свода черепа; кости таза; ребра (у взрослых поражаются чаще всего)
о Длинные трубчатые кости: 25-30%:
- Бедренная, большеберцовая, плечевая кости
- Может развиваться из любого места кости: диафиза (большинство), метафиза, эпифиза (сравнительно редко)
о Позвоночник: 9%
о Монооссальное поражение (66-75%) > полиоссальное поражение (25-34%):
- При полиоссальном поражении очаги появляются в течение 1-2 лет один за другим
о Редко наблюдается очаговый мягкотканный ЛКГ
• Размер: в среднем: 4-6 см, диапазон 1-15 см
(Слева) Рентгенография в ПЗ проекции: непосредственно после травмы визуализируется агрессивный проникающий очаг в средней части диафиза плечевой кости. Визуализируется рельефная периостальная реакция.
(Справа) МРТ, аксиальная проекция, режим Т2 с подавлением сигнала от жира: у этого же пациента визуализируется гиперинтенсивное мягкотканное образование вокруг патологически измененной кости. Периостальная реакция носит рельефный характер. Такие признаки, характеризующие агрессивный диафизарный очаг, типичны для саркомы Юинга, но могут также встречаться при остеомиелите или ЛКГ. (Слева) МРТ, сагиттальная проекция, режим Т1 с подавлением сигнала от жира, с контрастным усилением: у этого же пациента патологические изменения кости оказались более распространенными, чем ожидалось. Признаки абсцесса отсутствуют, что сужает дифференциально-диагностический поиск до саркомы Юинга и ЛКГ. По результатам биопсии был диагностирован ЛКГ.
(Справа) Рентгенография в ПЗ проекции, этот же пациент годом позже: визуализируются начальные признаки регресса патологического очага в виде мощной неагрессивной периостальной реакции. Ранние признаки ЛКГ могут вызывать тревогу, но со временем процесс становится менее агрессивным. (Слева) Рентгенография в боковой проекции: у молодого пациента визуализируется выраженно проникающий диафизарный очаг с рельефной периостальной реакцией. Наиболее вероятным и пугающим диагнозом при таких признаках будет саркома Юинга. По результатам биопсии был диагностирован ЛКГ.
(Справа) Рентгенография в ПЗ проекции:нечеткий литический очаг с периостальной реакцией. Учитывая ранний возраст пациента (18 месяцев), более вероятными, чем саркома Юинга, диагнозами будут являться ЛКГ, остеомиелит или метастазы нейробластомы. По результатам биопсии был диагностирован ЛКГ.
2. Рентгенография при лангергансоклеточном гистиоцитозе:
• Ранние очаги могут характеризоваться высокой агрессивностью при любой локализации:
о Проникающий очаг, без четких границ
о Склерозированный край отсутствует
о Периостальная реакция
о Прорыв кортикального слоя, мягкотканный компонент
о Деструктивные изменения могут развиваться стремительно:
- Деструкция развивается быстрее, чем при саркоме или остеомиелите
• Более зрелые очаги: менее агрессивные, хорошо отграниченные:
о Линейная периостальная реакция, при ее наличии
о Эндостальная фестончатость, минимальное расширение кости
о Мягкотканный компонент отсутствует
• Патологические очаги костей черепа:
о Хорошо отграниченный литический очаг
о Склерозированный край тонкий или отсутствует:
- Толстый склеротический край в фазу заживления
о Скошенный край: внутренняя и внешняя пластинки костей черепа поражаются в различной степени
о Возможно наличие секвестров
о Небольшие очаги могут сливаться в крупный хорошо отграниченный очаг
о При кортикальной деструкции может формироваться мягкотканный компонент
о Плавающие зубы при поражении верхней или нижней челюсти
• Патологические очаги позвонков:
о Преимущественное поражение тел:
- Диски, замыкательные пластинки и задние элементы не изменены
- Коллапс приводит к платиспондилии; при рентгенографии в передне-задней проекции визуализируется тонкая пластинка уплощенного позвонка, ножки дуги позвонка не изменены
о На ранней стадии процесса может визуализироваться параспинальное или эпидуральное образование
о На фоне лечения высота позвонка может частично восстанавливаться
3. КТ при лангергансоклеточном гистиоцитозе:
• Скошенность края и секвестры визуализируются более четко
• После установления диагноза КТ применяется для исследования легких
4. МРТ при лангергансоклеточном гистиоцитозе:
• Режим Т1: однородный сигнал низкой интенсивности
• Последовательности, чувствительные к жидкости: неоднородный сигнал высокой интенсивности
• Интенсивное накопление контрастного вещества патологически измененными зонами костного мозга и любыми мягкотканными компонентами; может быть неоднородным
• Почкующийся характер патологического очага помогает отличить его от более агрессивных опухолей
• Периостальная реакция отграничена зоной сигнала высокой интенсивности в последовательностях, чувствительных к жидкости и в режиме контрастного усиления
• Отек костного мозга, особенно при ранних активных патологических очагах
• Выраженный отек мягких тканей и фасции, что особенно характерно для агрессивного очага с прорывом кортикального слоя
5. Радионуклидная диагностика:
• В большинстве случаев при сцинтиграфии определяется повышенное накопление:
о 35% очагов имеют нормальные характеристики
• ПЭТ позволяет визуализировать на 35% больше новых или рецидивировавших очагов, чем рентгенография
6. Рекомендации по визуализации:
• Лучший метод визуализации:
о Рентгенография часто позволяет установить диагноз
о Агрессивные очаги требуют дальнейшего обследования и дифференциальной диагностики со злокачественными новообразованиями:
- МРТ для оценки области поражения
о ПЭТ/КТ или МРТ всего тела для выявления полиоссального характера поражения
(Слева) Рентгенография в боковой проекции: литический проникающий очаг в дистальном метафизе плечевой кости с периостальной реакцией. У пациента этой возрастной группы дифференциальная диагностика, вероятнее всего, будет проводиться между: саркомой Юинга, ЛКГ, остеомиелитом, метастазами и лейкемией.
(Справа) МРТ, корональная проекция, режим Т2 с подавлением сигнала от жира: патологический очаг характеризуется неоднородным сигналом высокой интенсивности. Хорошо визуализируется периостальная реакция. Подтверждается наличие прорыва кортикального слоя и мягкотканного компонента. (Слева) МРТ, корональная проекция, режим Т1 с подавлением сигнала от жира, с контрастным усилением: контрастное усиление патологического очага. МРТ помогает более точно определить объем поражения, но не позволяет гистологически дифференцировать новообразование. По результатам биопсии был диагностирован ЛКГ. Следует помнить, что на ранней стадии ЛКГ может протекать агрессивно и часто характеризуется прорывом кортикального слоя.
(Справа) Рентгенография в ПЗ проекции: полиоссальная форма ЛКГ с множественными литическими очагами в костях таза, ни один из которых не имеет агрессивных признаков. (Слева) Рентгенография в ПЗ проекции: хорошо отграниченный литический очаг в эпифизе головки левой бедренной кости. Дифференциальная диагностика проводится между ЛКГ, хондробластомой и абсцессом Броди.
(Справа) МРТ, корональная проекция, режим Т2 с подавлением сигнала от жира: у этого же па -циента визуализируется неоднородный, высокоинтенсивный эпифизарный очаг. Признаков суставного выпота или поражения физарной пластинки нет. По результатам биопсии был диагностирован ЛКГ. Эпифизарное поражение при ЛКГ встречается редко, но у детей возможно. Заболевание может протекать агрессивно, или, как в данном случае, не агрессивно.
в) Дифференциальная диагностика лангергансоклеточного гистиоцитоза:
1. Саркома Юинга:
• Литический агрессивный, проникающий очаг
• Агрессивная периостальная реакция, мягкотканный компонент
• Системные проявления: лихорадка, повышение СОЭ, лейкоцитоз как при ЛКГ
• Саркома Юинга способна метастазировать в другие кости и, потому, может имитировать полиоссальную форму ЛКГ:
о При саркоме Юинга, обычно, определяется один выраженный первичный очаг, а метастазы характеризуются меньшими размерами
• Лучевые признаки, позволяющие дифференцировать саркому Юинга и активный ЛКГ отсутствуют; необходима биопсия
2. Остеомиелит:
• Скорость развития деструктивных изменений аналогична раннему ЛКГ
• Литический, проникающий агрессивный очаг
• Периостальная реакция
• Возможно склеротическое реактивное костеобразование
• Системные проявления: лихорадка, повышение СОЭ, лейкоцитоз как при ЛКГ
• Рентгенография не всегда позволяет провести дифференциальную диагностику
• МРТ: визуализируются абсцессы в кости и/или в мягких тканях
3. Метастазы, костный мозг:
• У пациентов той же возрастной группы, что и ЛКГ наиболее часто встречаются метастазы нейробластомы
• Литические, агрессивные, проникающие
• Чаще всего имеют метафизарное расположение
4. Первичная мультифокальная костная фиброма:
• У детей лимфома носит мультифокальный характер в 50% случаев
• Литические ползучие проникающие очаги
• Распространение аналогично ЛКГ
(Слева) Рисунок, сагиттальная плоскость: пример поражения тела позвонка при ЛКГ. Межпозвонковый диск, замыкательные пластинки и задние элементы обычно не изменены. Полное поражение тела может привести к уплощению позвонка.
(Справа) КТ, режим 3D реконструкции, без контрастного усиления: крайне выраженное уплощение позвонка. Несмотря на тяжесть поражения тела позвонка, задние элементы остаются интактными. Платиспондилия может наблюдаться у детей с саркомой Юинга или метастазами нейробластомы, однако наиболее вероятно при ЛКГ, что и было подтверждено здесь результатами биопсии. (Слева) МРТ, сагиттальная проекция, режим Т1 с подавлением сигнала от жира, с контрастным усилением: пример типичного уплощения позвонка на фоне ЛКГ. Визуализируются признаки довольно часто встречающегося эпидурального распространения очага Он приподнимает заднюю продольную связку и распространяется под ней.
(Справа) МРТ, аксиальная проекция, режим Т1 с подавлением сигнала от жира, с контрастным усилением: необычный случай ЛКГ с поражением задних элементов и выраженным контрастным усилением ассоциированного мягкотканного компонента. Визуализируются признаки лимфаденопатии. Мягкотканный компонент характерен для ранней стадии ЛКГ, но претерпевает обратное развитие по мере эволюции патологического очага. (Слева) Рентгенография в боковой проекции: типичное уплощение С3 позвонка у ребенка с другими множественными костными очагами (здесь не отображаются). Наиболее вероятным диагнозом, с учетом сохранности межпозвонковых дисков и задних элементов, является ЛКГ, который и был подтвержден результатами биопсии.
(Справа) Рентгенография в боковой проекции, этот же пациент через три года: патологический очаг разрешился, а высота тела позвонка практически полностью восстановилась. Высота тела позвонка при ЛКГ может восстанавливаться на фоне лечения, поскольку замыкательные пластинки, в основном, остаются интактными.
г) Патология:
1. Общая характеристика:
• Этиология:
о Группа заболеваний, характеризующаяся патологической пролиферацией гистиоцитов ретикулоэндотелиальной системы
• Генетика:
о В ряде случаев ЛКГ носит клональный характер:
- В других случаях поликлональное происхождение предполагает реактивный характер заболевания
• Ассоциированные аномалии:
о Три формы гистиоцитоза:
- Болезнь Леттерера-Сиве (острая диссеминированная форма): 10%:
Острое развитие гепатоспленомегалии, сыпь, лимфаденопатия
Поражение скелета может отсутствовать
- Болезнь Хенда-Шуллера-Крисчена (хроническая диссеменированная форма): 20%:
Экзофтальм, лимфаденопатия (может быть массивной), гепатоспленомегалия, фиброз легких
- ЛКГ (с поражением костей и/или легких): 70%
2. Макроскопические и хирургические особенности:
• Мягкая красная опухоль
3. Микроскопия:
• Клетки Лангерганса: промежуточного размера с нечеткими цитоплазматическими границами:
о Цитоплазма от эозинофильной до прозрачной с овальными ядрами
• Клетки Лангерганса образуют кластеры
• Смешаны с воспалительными клетками: эозинофилами, лимфоцитами, нейтрофилами, плазматическими клетками
• Часто имеются зоны некроза: не являются маркером агрессивности
• Клетки Лангерганса содержат уникальные включения в цитоплазме в форме теннисной ракетки (гранулы Бирбека).
д) Клинические особенности:
1. Проявления:
• Типичные признаки/симптомы:
о Боль и отек
о Платиспондилия: боль в спине и/или неврологические симптомы
о Лихорадка, повышение СОЭ, лейкоцитоз, эозинофилия:
- Системные проявления в сочетании с агрессивными лучевыми признаками предполагают наличие других патологических очагов, также как и ЛКГ:
Остеомиелит или саркома Юинга
о Часто отмечается поражение легких и лимфатических узлов
• Другие признаки/симптомы:
о Утрата зубов при поражении нижней челюсти
о В 50-55% при ЛКГ отмечается поражение слизистых оболочек и кожи:
- Кожа является второй по частоте областью поражения после костей
2. Демография:
• Возраст:
о Широкий возрастной диапазон: от нескольких месяцев до 90 лет:
- Средний возраст установления диагноза 5-10 лет
о У 80-85% пациентов возраст не превышает 30 лет
о У 60% пациентов заболевание диагностируется в возрасте моложе 10 лет
о Для раннего возраста характерна диссеминированная форма (• Пол: мужчины > женщины (2:1)
• Этническая принадлежность:
о Чаще заболевают представители европеоидной расы
• Эпидемиология:
о 1% от всех костных опухолей и опухолеподобных образований
3. Течение и прогноз:
• Спонтанная ремиссия некоторых очагов может наступать в сроки от трех месяцев до двух лет
• Заболевание, обычно, имеет доброкачественное течение с выздоровлением на фоне лечения
• Смерть ассоциируется с острым развитием болезни Леттерера-Сиве
• Неопределённый прогноз имеет болезнь Хенда-Шуллера-Крисчена
4. Лечение:
• При стабильной форме и отсутствии риска перелома - наблюдение
• ЛКГ разрешается в течение 11-14 месяцев, в независимости от типа лечения:
о Кюретаж и использование костного трансплантата/стабилизация при болевом синдроме или риске перелома
о Инъекции стероидов
о Химиотерапия при полиорганном поражении
о Лучевая терапия при невозможности хирургического доступа:
- Риск развития радиационно-индуцированной саркомы
- По возможности не применяется; используется при наличии специфических показаний
• При поражении позвоночника может потребоваться декомпрессия, стабилизация
е) Диагностическая памятка:
1. Следует учесть:
• Ранняя агрессивная фаза ЛКГ может имитировать другие «мелко кругло голубоклеточные» опухоли
о Саркома Юинга, остеомиелит, нейробластома, метастазы, лимфома
• Поздняя фаза предполагает неагрессивное или доброкачественное развитие
2. Советы по интерпретации изображений:
• ЛКГ может характеризоваться стремительным развитием:
о Очаги могут появляться в течение двух недель
о Развивается гораздо быстрее, чем опухоль; несколько быстрее инфекционного процесса
о Последовательные рентгенограммы или анамнез (при его достоверности), подтверждающие такое быстрое развитие позволяют предполагать ЛКГ
ж) Список использованной литературы:
1. Amini В et al: Soft tissue Langerhans cell histiocytosis with secondary bone involvement in extremities: evolution of lesions in two patients. Skeletal Radiol. 42(9): 1301-9, 2013
2. Song YS et al: Radiologic findings of adult pelvis and appendicular skeletal Langerhans cell histiocytosis in nine patients. Skeletal Radiol. 40(11): 1421-6, 011
3. Arkader A et al: Primary musculoskeletal Langerhans cell histiocytosis in children: an analysis for a 3-decade period. J Pediatr Orthop. 29(2):201-7, 2009
Рентгенограмма, КТ при лангергансоклеточном гистиоцитозе челюсти
Лангергансоклеточный гистиоцитоз - лучевая диагностика
а) Терминология:
• Неопластическая пролиферация клеток Лангерганса
б) Визуализация:
• Локализация:
о Плоские кости: 65-70%
о Длинные трубчатые кости: 25-30%
о Позвоночник: 9%
• Монооссальное поражение (66-75%) встречается чаще, чем полиоссальное (25-34%)
• Ранние очаги могут характеризоваться высокой агрессивностью при любой локализации:
о Деструктивные изменения могут развиваться стремительно
• Более зрелые очаги: менее агрессивные, хорошо отграниченные
• Патологические очаги костей черепа:
о Скошенный край: внутренняя и внешняя пластинки костей черепа поражаются в различной степени
о Возможно наличие секвестров
• Поражение позвонков:
о Коллапс приводит к платиспондилии; при рентгенографии в передне-задней проекции визуализируется тонкая пластинка уплощенного позвонка, ножки дуги позвонка не изменены
• МРТ последовательности, чувствительные к жидкости: неоднородный сигнал высокой интенсивности:
о Интенсивное накопление контрастного вещества патологически измененными зонами костного мозга и любыми мягкотканными компонентами
о Выраженный отек мягких тканей, костного мозга и фасции, что особенно характерно для агрессивного очага с прорывом кортикального слоя, имитирующего злокачественную опухоль
(Слева) Рисунок в боковой проекции: множественные литические очаги костей черепа, которые можно наблюдать при лантергансоклеточном гистиоцитозе (ЛКГ). Очаги имеют скошенные края, указывающие на неравномерное поражение внутренней и наружной пластинок костей черепа.
(Справа) Рентгенография черепа в ПЗ проекции: типичная скошенность краев патологических очагов при классическом ЛКГ. Скошенность краев не является патогномоничной для ЛКГ, однако этот признак типичен и при наличии имеет высокую ценность. Кроме того, визуализируется секвестр, что является еще одним типичным признаком данного заболевания. (Слева) Рентгенография в косой проекции, выполненная тангенциально выпуклости на черепе: визуализируется литический очаг, занимающий диплоитическое пространство и характеризующийся скошенным краем. Такая картина типична для ЛКГ, особенно у детей.
(Справа) МРТ, косая проекция, режим Т1 с подавлением сигнала от жира, с контрастным усилением: неоднородный очаг с зоной контрастного усиления, окружающей низкоинтенсивную порцию очага. Обратите вниманию на различие в деструкции внутренней и внешней пластинок, подтверждающую причину скошенности края.
в) Клинические особенности:
• Широкий возрастной диапазон: от нескольких месяцев жизни до 90 лет:
о Средний возраст постановки диагноза: 5-10 лет
о Диссеминированная форма наблюдается у более младших пациентов
• Мужчины > женщины (2:1)
• Заболевание, обычно, имеет доброкачественное течение с выздоровлением на фоне лечения
• Смерть ассоциируется с острым развитием болезни Леттерера-Сиве
• Результаты лучевых исследований способны вводить в заблуждение, поскольку патологические очаги исходно могут характеризоваться ложно-агрессивными признаками
Гистиоцитоз X ( Гистиоцитоз из клеток Лангерганса , Легочная эозинофильная гранулема )
Гистиоцитоз Х – это системное заболевание, характеризующееся образованием специфических клеточных гранулем в различных органах и тканях. Наиболее типичные клинические проявления включают кожные высыпания, кашель, односторонний экзофтальм. Также наблюдаются выпадение зубов, увеличение периферических лимфатических узлов, признаки несахарного диабета (полиурия, полидипсия). Диагноз верифицируется путем гистологического исследования кожи, легких или лимфатических узлов. В качестве лечения применяются противовоспалительные препараты (глюкокортикостероиды), химиотерапевтические средства. В случае выраженного поражения легких производится трансплантация органа.
МКБ-10



Общие сведения
Гистиоцитоз Х (гистиоцитоз из клеток Лангерганса, легочная эозинофильная гранулема) – системная патология, при которой происходит активная пролиферация клеток Лангерганса в тканях легких, костей, центральной нервной системы, ретикуло-эндотелиальной системы (в печени, селезенке, лимфатических узлах). Течение заболевания варьирует в зависимости от формы и может быть доброкачественным со спонтанной ремиссией или быстропрогрессирующим с высокой вероятностью летального исхода. Распространенность гистиоцитоза составляет 5 на 1 000 000 человек. Преимущественно страдают дети, подростки, взрослые в возрасте 20-30 лет. Гистиоцитоз встречается только у представителей белой расы, чаще у мужчин (соотношение с женщинами 2:1).

Причины
На сегодняшний день точная причина гистиоцитоза неизвестна. Предполагается роль иммунной аутоагрессии, вызванной инфицированием вируса герпеса 6-го типа. До сих пор ведутся научные дебаты о наследственной природе заболевания. У 50% пациентов в патологических клетках Лангерганса была обнаружена соматическая мутация гена V600E, кодирующего внутриклеточный сигнальный белок BRAF. Табакокурение рассматривается как один из основных факторов риска (более 90% больных являются курильщиками). Подтверждением этого служит тот факт, что симптоматика уменьшается после прекращения курения даже без применения какого-либо лечения.
Патогенез
Механизм развития гистиоцитоза изучен недостаточно. Основным звеном патогенеза считается накопление в тканях дендритных клеток (клеток Лангерганса, или гистиоцитов). Дендритные клетки синтезируются в костном мозге и мигрируют в дерму, паренхиму легких, ретикулоэндотелиальную систему и т.д. Их основная функция заключается в поглощении антигенов, поступающих из окружающей среды, и презентации Т и В-лимфоцитам для формирования иммунного ответа. После контакта с гистиоцитами лимфоциты начинают выделять провоспалительные цитокины и медиаторы, повышающие активность гистиоцитов и придающие им высокую подвижность.
При гистиоцитозе по неизвестным причинам у дендритных клеток нарушается процесс апоптоза (запрограммированной клеточной гибели). В сочетании с выделяемыми лимфоцитами факторами роста это приводит к их интенсивной пролиферации с последующим слиянием с эозинофилами. В результате образуются гигантоклеточные гранулемы, которые постепенно начинают замещать нормально функционирующую ткань того или иного органа. Присутствие большого количества Т-лимфоцитов в гранулемах позволяет предположить наличие специфического антигена.
Классификация
По локализации очагов выделяют моносистемную форму с единичным или множественным поражением одной анатомической области и мультисистемную форму с признаками нарушения функции органов или без них. Традиционно различают следующие клинические формы:
- Диссеминированная (первично-острая, болезнь Абта—Леттерера—Сиве). Течение напоминает тяжелую системную инфекцию. Характеризуется быстрой генерализацией процесса, прогрессированием легочной недостаточности и высокой частотой летальности. Чаще возникает у детей от 6 месяцев до 2 лет.
- Первично-хроническая (болезнь Хенда—Шюллера—Крисчена). Течение также системное, но более благоприятное, различные органы вовлекаются постепенно. Типична триада Крисчена – несахарный диабет, односторонний экзофтальм и деструкция плоских костей черепа. Встречается у детей и подростков.
- Эозинофильная гранулема(болезнь Таратынова). Наиболее доброкачественный вид. Преимущественная локализация гранулем - кости и легкие. В большинстве случаев развивается у взрослых.
Симптомы гистиоцитоза
Клиническая картина крайне разнообразна. Заболевание начинается с появления общей слабости, повышения температуры тела, которая в основном бывает субфебрильной, но может достигать 40°С. Возможны диспепсические нарушения – тошнота, рвота, диарея. Кожа покрывается зудящими очагами гиперемии с чешуйками или корочками. Иногда наблюдаются геморрагические элементы, длительно незаживающие язвы. Высыпания присутствуют на коже головы, наружного слухового прохода, в области естественных складок (паховой, подмышечной). Увеличиваются лимфатические узлы по всему телу.
Возникает одышка, упорный сухой кашель и боли в грудной клетке. Затруднение дыхания может беспокоить только во время физической нагрузки или присутствовать даже в покое. Присоединяются тупые боли или тяжесть в правом подреберье из-за увеличения печени (гепатомегалии). При выраженном поражении печени кожа приобретает желтушный оттенок. Увеличение селезенки сопровождается болью в левом подреберье. Некоторые пациенты испытывают боль в костях. Деструкция костей глазницы ведет к образованию экзофтальма, чаще одностороннего. Боль в ухе ошибочно диагностируется как бактериальный или грибковый отит и безуспешно лечится антибактериальными и противогрибковыми препаратами. Остеолизис нижней челюсти приводит к периодонтитам и выпадению зубов.
При длительном течении гистиоцитоза больной начинает терять вес. В тяжелых случаях встречаются признаки костномозговой недостаточности – анемический синдром (бледность кожи, головокружение, учащенное сердцебиение), склонность к кровотечениям, сниженная сопротивляемость к инфекциям. Формирование гистиоцитарных гранулем в задней доле гипофиза вызывает угнетение выработки антидиуретического гормона. В результате развивается симптоматика несахарного диабета – сухость во рту, постоянная жажда (полидипсия) и повышенное мочеотделение (полиурия).
Осложнения
Широкая вариативность клинической картины при гистиоцитозе обусловливает разнообразие осложнений. Наиболее характерными считаются патологические переломы костей, особенно компрессионный перелом позвоночника. Типичные осложнения со стороны легких – легочная артериальная гипертензия вследствие диффузного фиброза легочной ткани, спонтанный пневмоторакс из-за разрыва тонкостенных булл. Массивная инфильтрация печени вызывает цирроз с печеночно-клеточной недостаточностью. К редким осложнениям относятся неблагоприятные последствия дефицита антидиуретического гормона (несахарного диабета) в виде гиперосмолярной гипогидратации, проявляющейся двигательным беспокойством, мышечными судорогами, нарушением сознания, вплоть до глубокой комы.
Диагностика
Пациентами с гистиоцитозом занимаются различные врачи – гематологи, пульмонологи, педиатры. Профиль специальности зависит от возраста больного и преимущественно пораженного органа. При общем осмотре отмечаются цианоз (синюшность) губ, участие в дыхании вспомогательной мускулатуры (при дыхательной недостаточности). При аускультации легких выслушивается жесткое дыхание, сухие хрипы по всем легочным полям. Дополнительное обследование включает:
- Лабораторные тесты. В общем анализе крови обнаруживаются ускорение скорости оседания эритроцитов, иногда эозинофилия и панцитопения (уменьшение эритроцитов, тромбоцитов и лейкоцитов). В биохимии крови может прослеживаться увеличение печеночных ферментов (АЛТ, АСТ) и повышение осмолярности плазмы. При печеночной недостаточности изменяются показатели коагулограммы (удлинение протромбинового времени, гипофибриногенемия). В анализе мочи наблюдается низкая относительная плотность (гипостенурия).
- Инструментальные исследования. При рентгенографии скелета находят очаги деструкции и остеолизиса, особенно выраженные в плоских костях черепа и длинных трубчатых костях. На рентгенограмме органов грудной клетки видны двусторонние мелкоочаговые затемнения (узелки, буллы), усиление легочного рисунка. Для более точной визуализации легочной ткани назначается компьютерная томография легких высокого разрешения, позволяющая определить их ячеистую деформацию. Результаты измерения функции внешнего дыхания (спирографии) показывают ухудшение диффузионной емкости легких.
- Верифицирующие тесты. Позволяют достоверно установить диагноз гистиоцитоза. При гистологическом исследовании биоптата (чаще кожи, лимфатических узлов или легких) выявляется избыточное количество гигантских клеток Лангерганса с эозинофильной цитоплазмой, бобовидной формой ядра, отсутствием ядрышек. Для идентификации поверхностных специфических маркеров гистиоцитоза (CD 1а и лангерина) проводится иммуногистохимический анализ.
Дифференциальный ряд включает большое количество нозологий и зависит от клинических симптомов гистиоцитоза. Кожные высыпания нужно дифференцировать с экземой, псориазом, атопическим дерматитом. Поражение легких следует отличать от туберкулеза, саркоидоза, лимфогранулематоза. Генерализованный гистиоцитоз дифференцируют с гематологическими заболеваниями (гемофагоцитарный синдром, острый лейкоз). Очаги деструкции костей требуют исключения гиперпаратиреоза, множественной миеломы, остеомиелита.

Рентгенография легких. Диффузные двусторонние узловые затемнения и небольшие кисты в верхней и средней доле
Лечение гистиоцитоза
Пациенты обязательно должны быть госпитализированы в стационар. При тяжелой дыхательной недостаточности показаны ингаляции кислорода или перевод на искусственную вентиляцию легких. При наличии признаков костномозговой недостаточности прибегают к переливанию компонентов крови и применению гранулоцитарного колониестимулирующего фактора.
Этиотропной терапии гистиоцитоза Х не существует. Наиболее важный этап в лечении – отказ от курения. Прекращение курения вызывает улучшение клинической, лабораторной, рентгенологической картины. В качестве патогенетической терапии используют глюкокортикостероиды (преднизолон, метилпреднизолон), химиотерапевтические средства (винбластин, меркаптопурин, этопозид).
Для лечения несахарного диабета назначается заместительная гормональная терапия аналогами вазопрессина (десмопрессин) в виде интраназального спрея или в таблетированной форме. При небольших остеолитических очагах выполняют кюретаж, при выраженной инфильтрации костей – резекцию или дистанционную гамма-терапию. При массивном деструктивном процессе в легочной ткани проводится трансплантация легких.
Прогноз и профилактика
Течение и прогноз при гистиоцитозе Х определяется формой заболевания. Первично-острая форма характеризуется быстропрогрессирующим течением с неблагоприятным прогнозом. Смерть наступает в 70-80% случаев от легочно-сердечной недостаточности. Первично-хроническая форма и эозинофильная гранулема имеют более доброкачественное течение. Риск летальности составляет 15% и 1,5% соответственно. Иногда происходит спонтанное выздоровление. Так как причина развития гистиоцитоза неизвестна, эффективных методов профилактики не разработано. Уменьшить риск возникновения и рецидива может отказ от табакокурения.
1. Доброкачественное течение гистиоцитоза Х/ Шихнебиев Д.А., Эседов Э.М., Джалилова Л.М.// Клиническая медицина. – 2002 - №7.
2. Роль дерматолога в диагностике гистиоцитоза из клеток Лангерганса/ Мошкалова И.А.// Учебные записки СПбГМУ им. акад. И.П. Павлова. - 2001, т. VIII, №4.
4. Легочный гистиоцитоз Х — современные представления, диагностика и тактика лечения/ Корнев Б.М., Коган Е.А., Попов Е.Н. и др.// Терапевтический архив - 2003 - №5.
2. Синонимы:
• Гистиоцитоз X, идиопатический гистиоцитоз, лангергансоклеточ-ная болезнь, лангерансоклеточный гранулематоз, лангергансо-клеточная гранулема, эозинофильная гранулема (ЭГ)
3. Определение:
• Группа заболеваний ретикулоэндотелиальной системы, характеризующихся пролиферацией клеток Лангерганса
1. Общая характеристика:
• Лучший диагностический критерий:
о Хорошо отграниченное («выштампованное») просветление без кортикальной пластинки по краю
о При поражении альвеолярного отростка зубы могут выглядеть «парящими в воздухе»
• Локализация:
о Поражения костей черепа, бедренной кости, челюстей, ребер, длинных костей, позвонков, таза
о 50% поражений костей наблюдаются в костях черепа
о Челюстно-лицевая область: поражение челюстей > мягких тканей (2:1):
- Поражение челюстей наблюдается в 10-20% всех случаев
- Нижняя > верхняя челюсть:
Задние > передние отделы, преимущественно тело и ветвь нижней челюсти
• Размер:
о Мелкие («выштампованные»)-крупные очаги неправильной формы
• Морфология:
о Округлые или овальные очаги в дебюте заболевания
о Возможно увеличение размеров и сливание очагов по мере прогрессирования

(Слева) На рентгенограмме черепа в прямой проекции визуализируются два очага ЛКГ в лобной кости: меньший (округлый с ровными контурами) и больший (неправильной формы). Для описания подобных поражений используется термин «географический череп». Очаги также определяются в нижней челюсти.
(Справа) На рентгенограмме в косой боковой проекции у этого же пациента определяется «выскобленный» очаг вокруг мезиального корня формирующегося 1-го моляра. Пациент страдает хроническим диссеминированным ЛКГ, клинически проявляющимся экзофтальмом.
2. Рентгенография при лангергансоклеточном гистиоцитозе челюсти:
• Интра- и экстраоральная рентгенография:
о Утрата костной ткани вокруг зуба на всем протяжении
о Может имитировать заболевание периодонта: следующие признаки могут помочь в дифференциальной диагностике:
- Заболевание периодонта начинается с альвеолярного гребня; очаги ЛКГ обычно центрированы возле средней трети корня
- В отличие от заболеваний периодонта кость может выглядеть «выскобленной»
о Зубы могут выглядеть «парящими»
о На панорамных изображениях могут обнаруживаться периостальные наслоения вдоль кортикальной пластинки
• Краниография:
о Позволяет обнаружить поражения черепа:
- «Выштампованные», относительно хорошо отграниченные
- Очаги могут иметь неправильную форму и больший размер, иногда создавая картину «географического черепа»
3. КТ при лангергансоклеточном гистиоцитозе челюсти:
• КТ в костном окне и КЛКТ:
о Оценка размеров остеолитических очагов в верхней и нижней челюсти
о На КЛКТ также могут обнаруживаться поражения черепа (в зависимости от поля зрения)
о Позволяют лучше идентифицировать периостальную реакцию
4. МРТ при лангергансоклеточном гистиоцитозе челюсти:
• Т1 ВИ:
о Изоинтенсивный мышцам сигнал, умеренное контрастирование
• Т2 ВИ:
о Гиперинтенсивный сигнал
4. Сцинтиграфия:
• Активное накопление Тс-99m в очагах помогает в оценке распространенности заболевания

(Слева) На краниограмме в боковой проекции у ребенка с хроническим диссеминированным ЛКГ визуализируются типичные мелкие «выштампованные» просветления.
(Справа) На корональной КТ в костном окне у женщины 28 лет в ветви нижней челюсти справа визуализируются мелкие эозинофильные гранулемы с четкими контурами. Обратите внимание на истончение (но не перфорацию) щечной кортикальной пластинки. Патологический очаг, лежащий под нижнечелюстным каналом, распространяется в сторону щечной кортикальной пластинки.
в) Дифференциальная диагностика лангергансоклеточного гистиоцитоза челюсти:
1. Локальный агрессивный периодонтит:
• Локальное агрессивное заболевание периодонта:
о С преимущественным поражением первых моляров и резцов
о Дугообразные просветления вследствие утраты костной ткани в межзубных пространствах
• Пациенты моложе (подростки)
2. Плоскоклеточный рак:
• Солитарное плохо отграниченное просветление:
о Множественные поражения позволяют исключить этот диагноз
• Расшатывание зубов из-за деструкции костной ткани возле корней зубов
• Может обнаруживаться сопутствующая мягкотканная опухоль
• Возрастная группа обычно старше
3. Остеомиелит:
• Плохо отграниченный рентгенонегативный или смешанный очаг
• Часто можно обнаружить источник инфекции
• Ключевой признак-секвестрация
• Может наблюдаться периостальная реакция
4. Метастазы:
• Плохо отграниченные просветления
• Могут расти в пространстве перидонтальной связки
• Первичная опухоль обычно известна
5. Лимфома:
• Плохо отграниченное просветление
• Растет преимущественно в пространстве периодонтальной связки
• Может разрушать фолликул формирующегося зуба
• При наличии эозинофилов в небольшом количестве лимфома гистологически может напоминать ЭГ
6. Лейкоз:
• Мультифокальные просветления
• Расширение пространства периодонтальной связки
• Лихорадка, недомогание

(Слева) На аксиальной КТ в костном окне у этой же пациентки визуализируется очаг в ветви и отдельно лежащий очаг спереди от него, хуже отграниченный и с более выраженной деструкцией. Между очагами визуализируется нижнечелюстной канал.
(Справа) На корональной КТ в костном окне у этой же пациентки определяется деструкция язычной кортикальной пластинки, обусловленная очагом большего размера. Обратите внимание на нижнечелюстной канал внизу. В этом случае имеет место моно-стотическая эозинофильная гранулема с изолированным поражением ветви справа: прогноз благоприятный.
1. Стадирование, градации, классификация:
• Острый диссеминированный (болезнь Леттерера-Сиве): полиорганное поражение:
о Гепатомегалия, спленомегалия, кровоизлияния, анемия, лимфаденопатия, поражение тимуса и костного мозга, высыпания на коже
о Скорее всего, представляет злокачественный неопластический процесс
о 10% всех случаев ЛКГ
• Хронический диссеминированный (болезнь Хэнда-Шюллера-Крисчена):
о Триада: множественные поражения костей, несахарный диабет, экзофтальм о 20% всех случаев ЛКГ
• Хронический локализованный (эозинофильная гранулема): моностотическое или полиостотическое поражение костей без вовлечения внутренних органов:
о При полиостотической форме обычно поражаются 2-4 кости
о Эозинфильная гранулема составляет 60-70% всех случаев ЛКГ
2. Микроскопия:
• Скопления эозинофилов между клетками, напоминающими гистиоциты
• Иногда обнаруживаются плазматические клетки, лимфоциты, многоядерные гигантские клетки
• Для установления диагноза необходимо обнаружение клеток Лангерганса:
о Клетки Лангерганса: дендритные одноядерные клетки, обнаруживаемые преимущественно в эпидермисе и костном мозге:
- Представляют антигены Т-лимфоцитам
- Содержат гранулы Бирбека в цитоплазме:
Что отличает клетки Лангерганса от других одноядерных фагоцитов
- Иммуногистохимия: CD1 выраженная (+) реакция; S100 (+)
1. Проявления:
• Типичные признаки/симптомы:
о Подвижность зубов:
- Отсутствие заживления дефектов после утраты зубов
о Интраоральная опухоль/отек
о Боль
• Другие признаки/симптомы:
о Гингивит/кровоточивость
о Язвы
о Нарушение заживления
о Галитоз
2. Демография:
• Возраст:
о Острый диссеминированный: дети < 3 лет
о Хронический диссеминированный: 1-е десятилетие
о Локализованный (эозинофильная гранулема): дети старшего возраста → взрослые
• Пол:
о М=Ж; согласно некоторым данным, М>Ж при локализованной форме (2:1)
• Эпидемиология:
о 2-5 случаев на миллион
о 50% < 15 лет
3. Течение и прогноз:
• Общий прогноз зависит от возраста дебюта заболевания и степени органной дисфункции
• Локализованная форма: благоприятный:
о Сообщается о спонтанной ремиссии эозинофильной гранулемы после биопсии
о А также о регенерации костной ткани в патологическом очаге и неправильном сращении после патологического перелома у взрослых в отсутствие оперативного вмешательства
• Хронический диссеминированный тип: достаточно благоприятный:
о Возможно прогрессирование с развитием летального диссеминированного заболевания (10%)
• Острый диссеминированный: неблагоприятный:
о В младенчестве всегда приводит к гибели
о Прогноз слегка улучшается в возрасте старше двух лет
4. Лечение:
• Эозинофильная гранулема: локализованные поражения нижней/верхней челюсти:
о Хирургическое (выскабливание)
о Низкодозовая лучевая терапия ± химиотерапия в случае поражений, недоступных для оперативного лечения:
- С целью достижения ремиссии у пациентов младшего возраста
- Лучевая нагрузка обычно о Уровень рецидивов: 1,6-25%
о После комбинированного лечения (операция+лучевая терапия) частота рецидивов ниже по сравнению с оперативным вмешательством
о При некоторых поражениях с успехом применяются кортикостероиды, вводимые в патологический очаг
• Хронический диссеминированный тип:
о Химиотерапия: винбластина сульфат, винкристин, этопозид ± кортикостероид (преднизон):
- Преднизон считается препаратом, снижающим частоту рецидивов
• Острый диссеминированный: полихимиотерапия
е) Диагностическая памятка. Следует учесть:
• Хотя очаги множественной миеломы (ММ) описываются аналогично (как «выштампованные»), пациенты с ММ намного старше
Эозинофильная гранулема ( Болезнь Таратынова )
Эозинофильная гранулема – это очаговая форма гистиоцитоза из клеток Лангерганса, которая проявляется опухолеподобными очагами в костях. Основной причиной заболевания называют генетические мутации, которые запускают аномальную пролиферацию клеток. Проявления патологии зависят от локализации опухоли: боли в костях, патологические переломы, выпадение зубов, экзофтальм и нарушения зрения. Для диагностики гранулемы назначают рентгенографию костей, исследования крови, гистологический анализ костных очагов. Лечение проводится хирургическим способом (кюретаж, резекция), по показаниям дополняется фармакотерапией и лучевой терапией.

Эозинофильная гранулема встречается с частотой 3-5 случаев на 1 млн. населения, в основном в подростковом и юношеском возрасте. Мужчины болеют в 2 раза чаще женщин. Случаи заболевания среди пациентов среднего и пожилого возраста встречаются крайне редко. Этот вид доброкачественной опухоли составляет менее 1% всех объемных новообразований костной ткани и до 80% случаев гистиоцитоза. В отечественной литературе гранулему иногда называют болезнью Таратынова по имени российского патологоанатома, который впервые описал нетипичные очаги поражения в костной ткани.

Несмотря на многочисленные научные изыскания, до сих пор не удалось установить этиологическую структуру эозинофильной гранулемы и других вариантов гистиоцитоза. Большое значение придают генетическим мутациям. Чаще всего встречается врожденная аномалия гена BRAF, который отвечает за деление и выживание разных типов клеток. Второй по частоте является мутация гена MAP2K1, который кодирует белки сигнального пути и участвует в процессе клеточной пролиферации.
Образование очага эозинофильной гранулемы связывают с пролиферацией клеток Лангерганса, которые имеют костномозговое происхождение. Они относятся к компонентам иммунной системы и участвуют в первом этапе защиты: выполняют антигенпредставляющую функцию. При гистиоцитозе клетки начинают активное деление в костной ткани, где образуют опухолевые очаги. Этому способствует повышенная экспрессия факторов пролиферации и ингибиторов апоптоза.
Гистиоциты и эозинофилы патологического происхождения, которые составляют гранулему, находятся на разных стадиях дифференцировки. Они умеренно пролиферируют, плохо восприимчивы к физиологическому апоптозу, из-за чего длительно персистируют в очаге. Такие особенности в сочетании моноклональностью клеток и избыточной активацией Т-супрессоров позволяют рассматривать очаговый гистиоцитоз как неопластический процесс.

Симптомы эозинофильной гранулемы
Небольшие по размеру опухоли, которые расположены в костях скелета тела, длительное время протекают бессимптомно. Изредка пациенты жалуются на умеренные боли в костях, отечность над очагом поражения. Значимые клинические проявления наблюдаются при увеличении опухоли в размерах и уменьшении прочности кости. Возможны патологические переломы, которые возникают при минимальном механическом повреждении конечности либо вовсе не связаны с травмой.
Для эозинофильной гранулемы типично поражение костей верхней и нижней челюсти. При такой локализации очага возможно расшатывание и выпадение зубов у пациентов молодого возраста, патологические переломы челюсти, сложности при проведении стоматологических манипуляций. Изредка болезнь протекает по типу мультисистемного поражения, когда в процесс вовлекаются другие органы. Гистиоцитоз может затрагивать печень, селезенку, кроветворную систему
Болезнь характеризуется полиморфными кожными высыпаниями. Они располагаются на любом участке тела, в том числе на волосистой части головы и в области гениталий. Сначала возникают красные пятна и шелушащиеся бляшки, которые постепенно превращаются в выступающие опухолевидные образования. Узлы приобретают синюшно-багровый цвет, достигают 3-4 см в размерах. На слизистых оболочках ротовой полости и половых органов образуются длительно не заживающие язвы.
Локализованная форма гистиоцитоза отличается благоприятным доброкачественным течением. Основной проблемой считается нарушение целостности костных структур: патологические переломы, возникающие в юном возрасте, нарушают нормальную анатомию и функциональную способность конечности. Для купирования хронических костных болей пациенты могут использовать нестероидные противовоспалительные, бесконтрольный прием которых вызывает НПВП-гастропатию.
При расположении эозинофильной гранулемы в височной кости возможна частична обструкция слухового прохода, которая способствует рецидивирующему наружному отиту. Если очаг расположен вблизи глазницы, развивается экзофтальм и нарушения зрения различной степени тяжести. Поражение позвонков, особенно у детей, чревато нарушениями осанки и стойкой деформаций позвоночного столба.
При клинических признаках эозинофильной гранулемы пациенты чаще всего обращаются к дерматологу или ортопеду-травматологу, после чего получают направление на консультацию онкогематолога. На первом этапе диагностики проводится осмотр кожи и видимых слизистых оболочек, пальпация зон болезненности, выяснение условий и давности появления симптомов. Для подтверждения диагноза назначаются следующие методы исследования:
- Рентгенография костей. При рентгенологическом исследовании определяются единичные или множественные опухолевидные образования, участки деструкции, которые могут располагаться как в трубчатых, так и в плоских костях. При подозрении на эозинофильную гранулему обязательно проводят рентгенографию челюстей.
- УЗИ органов живота. Исследование назначается при подозрении на многоочаговую форму гистиоцитоза, которая протекает с поражением внутренних органов. В таком случае при диагностике обнаруживаются объемные новообразования с неоднородной эхоструктурой в печени, селезенке, внутрибрюшных лимфоузлах.
- Гистологический анализ. Для эозинофильной гранулемы характерны инфильтраты из крупных овальных клеток, которые имеют ядра неправильной формы и большое количество цитоплазмы. При иммуногистохимии подтверждается наличие клеток Лангерганса, большого количества эозинофилов, ограниченного числа лимфоцитов и нейтрофилов.
- Анализы крови. В периферической крови у большинства пациентов обнаруживают гипохромную анемию с анизоцитозом и пойкилоцитозом. Реже встречается нейтрофилез со сдвигом влево, моноцитоз, тромбоцитопения. При выполнении коагулограммы обнаруживают повышение свертывающей способности крови.
- Анализ на онкомаркеры. Для исключения рака костей пациентам проводят исследование крови на тартрат-резистентную кислую фосфатазу. Рост уровня этого маркера является достоверным признаком повышения активности остеокластов и развития пролиферативного процесса.
- Анализ генаBRAF. Молекулярно-генетический метод исследования проводится ля уточняющей диагностики гистиоцитоза. Выявление генной мутации в клетках гранулемы помогает подтвердить диагноз, наличие такой же аномалии в периферической крови требуется для установления группы риска пациента с гистиоцитозом.
Дифференциальная диагностика
Для постановки диагноза необходимо дифференцировать заболевание с другими причинами появления объемных новообразований костей. В процессе обследования исключают онкопатологию:
- остеогенный рак;
- саркому;
- лимфому;
- миеломную болезнь.
При выраженных болях и припухлости проводится дифференциальная диагностика с остеомиелитом. Кожные проявления требуют дифференцировки с синдромом Папийона-Лефевра.
Лечение эозинофильной гранулемы
Хирургическое лечение
При солитарных очагах в костной ткани основным методом терапии является кюретаж с последующим восстановлением целостности кости. В связи с онкологической настороженностью зачастую проводится широкая резекция эозинофильной гранулемы, которая обеспечивает полную ликвидацию новообразования, однако имеет нежелательный функциональный результат. После такой операции потребуется костная пластика для замещения ятрогенного дефекта.
Консервативная терапия
Фармакотерапия и облучение оправданы при множественной гранулеме, вовлечении в патологический процесс кожи и внутренних органов. Общепринятые протоколы терапии отсутствуют, поэтому программа подбирается индивидуально с учетом особенностей заболевания у конкретного больного. Медикаментозная терапия включает цитостатики, которые применяются для замедления пролиферации клеток, и глюкокортикоиды, стимулирующие репарацию после кюретажа.
Локализация гранулем в костях конечностей и черепа открывает широкие возможности лучевой терапии. Облучение проводится как альтернатива хирургическому вмешательству, если новообразование недоступен для кюретажа, либо пациент имеет противопоказания к оперативному лечению. После радиотерапии полная ремиссия наблюдается у 85% пациентов, причем контроль над солитарным очагом болезни удается получить в 95% случаев.
Важное место в терапевтической программе занимает лечение кожных очагов гистиоцитоза. Терапевтическая программа подбирается только после гистологического исследования биоптатов. Пациентам показана системная терапия, которая включает препараты альфа-интерферона, метотрексата и леналидомида. Они обладают противовоспалительными, антиангиогенными и иммуномодулирующими свойствами.
Солитарная эозинофильная гранулема признана наиболее доброкачественной формой гистиоцитоза. Более благоприятный прогноз для больных с изолированными местными проявлениями и отсутствием системных осложнений болезни. Многоочаговый вариант гистиоцитоза протекает менее благоприятно. Точные причины и механизм развития заболевания пока не ясны, поэтому эффективные меры профилактики отсутствуют.
1. 1. Гистиоцитоз из клеток Лангерганса у взрослых: современные возможности терапии/ В.Д. Латышев, Е.А. Лукина// Клиническая онкогематология. – 2021. – №14.
2. 2. Гистиоцитоз из клеток Лангерганса (гистиоцитоз Х): клиническое наблюдение/ И.А. Горланов/ Вестник дерматологии и венерологии. – 2013. – №1.
4. Доброкачественное течение гистиоцитоза Х/ Шихнебиев Д.А., Эседов Э.М., Джалилова Л.М.// Клиническая медицина. – 2002 - №7.
Читайте также:
- Лучевая диагностика опухоли оболочки нерва челюсти
- Классификация легочной гипертензии. Клиника легочной гипертензии
- Паллиативное лечение. Умышленная смерть пациента
- Желудочно-кишечная непроходимость. Газы в желудочно-кишечном тракте - метеоризм
- Капсид вируса. Функции капсида вирусов. Капсомеры. Нуклеокапсид вирусов. Спиральная симметрия нуклеокапсида. Кубическая симметрия капсида.
